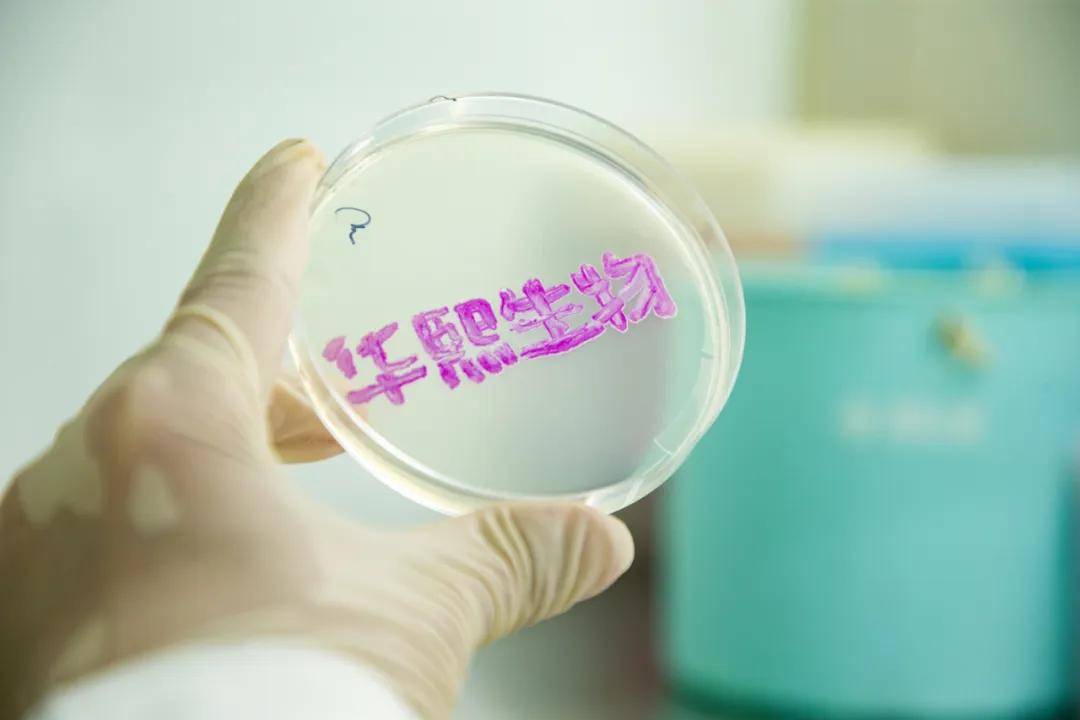

要“走得更快”還是“走得更穩” ,華熙生物給出了自己的答案_風聞
子弹财经-子弹财经官方账号-子弹财经(zidancaijing)20分钟前

出品 | 子彈財經
作者 | 六喜
編輯 | 閃電
美編 | 倩倩
審核 | 頌文
華熙生物,這家在生物科技領域飛速發展的企業,近日發佈了其2023年年報及2024年第一季度報告,顯示出公司在波動中前行的態勢。
儘管2023年整體營收和淨利潤均出現同比下滑,但進入2024年第一季度,華熙生物便以營收和淨利潤的雙增長為全年發展開了個好頭。其中,2024年一季度營收13.61億元,同比增長4.24%;歸母淨利潤2.43億元,同比增長達到21.39%。
回顧華熙生物的成長曆程,自2019年上市以來,公司在短短五年內從10億級規模迅速成長至60億級,不僅在規模上實現了跨越式發展,更在業務佈局和戰略方向上持續向合成生物全產業鏈公司穩步邁進。
然而,面對快速擴張帶來的挑戰,華熙生物並未選擇盲目追求速度,而是主動放緩腳步,對醫療終端業務和功能性護膚品業務進行內部調整。特別是在2023年,公司自我變革的腳步明顯加速。
雖然調整過程中難免會帶來一些陣痛,但華熙生物顯然已經做好了準備。隨着調整優化的逐步推進,華熙生物的新篇章將會如何展開?
1、從10億級到60億級從10億級規模,到60億級,華熙生物只用了5年的時間。
2019年,華熙生物正式登陸A股市場,開啓了持續幾年的快速增長。這一年,公司實現營收18.86億元,同比增幅達到49.28%。此後的三年,華熙生物收入增速持續保持在兩位數,2021年一度高達87.93%。

(圖 / 東方財富Choice)
到了2022年,華熙生物營收首次突破60億元,達到63.59億元。
2023年,受到內外部環境的影響,華熙生物實現營業收入60.76億元,同比微降4.45%,歸屬於上市公司股東淨利潤5.93億元。

儘管華熙生物2023年的業績並未保持如過去般的迅猛增長態勢,導致市場上出現一些對其發展潛力的質疑聲音,甚至有人悲觀地認為華熙生物的故事已經告一段落。然而,這種看法顯然過於片面,實際情況遠非如此。
事實上,華熙生物在過去的幾年中不僅實現了規模上的跨越式增長,更在業務佈局和戰略方向上進行了更為明確和穩健的調整。公司從原料業務起家,逐步拓展至醫療終端業務、功能性護膚品業務及功能性食品業務等多個領域,形成了多元化的業務格局。
在發展過程中,華熙生物始終聚焦合成生物學領域,堅持其作為生物科技公司和生物材料公司的整體定位。公司用科技力打造產品力,不斷向合成生物全產業鏈公司邁進,展現了其強大的研發實力和市場競爭力。
然而,隨着業務規模的迅速擴張,內部組織管理面臨的挑戰也日益凸顯。為了確保公司的持續發展,華熙生物主動對相關業務進行了調整優化。並且,這種主動調整其實已經為業務帶來了正面的反饋。
2023年,公司原料業務實現收入11.29億元,同比增長15.22%。醫療終端業務實現收入10.90億元,同比增長高達58.95%。
從數據來看,華熙生物在原料業務上保持着一如既往的優勢,醫療終端業務也已實現了規模化增長。這兩大業務板塊作為公司的根基和技術高度的代表,為公司的持續發展提供了堅實的支撐。同時,功能性護膚品業務也度過了初創高增期,進入品牌建設期,發展趨於穩健和平衡。
對於公司的發展戰略,華熙生物董事長兼總裁趙燕在近期的一次交流中強調,公司的發展底色應建立在生物技術和生命科學的基礎上。她認為,未來很多科技創新來源於跨學科的共創合作,未來的消費品業務和醫美業務將受到其他行業、其他領域越來越大的影響,而生物材料和生命科學的發展將是最大的影響因素。
“現在華熙生物有非常大的消費品業務,我們需要不斷學習怎麼把握不同時代的獲客機制,怎麼優化營銷組織,但建立基於營銷領先的組織不應該是華熙生物的基本底色。這就是為什麼在把握流量切換和優化營銷組織時,我一直要求不能走其他企業的老路。我們的底色要建立在生物技術和生命科學的基礎上,這無關外界的理解,這是我們自己的取捨,關係到我們自己的業務和組織布局選擇。”趙燕表示。
整體而言,華熙生物在經歷數年的迅猛增長與規模化的拓展之後,並沒有停滯不前,而是將視線轉向了更為深遠的未來。公司正圍繞其發展的基石和核心戰略方向進行深入的思考與調整,這一過程並非預示着增長的終結,而是為即將到來的新一輪加速發展奠定堅實的基礎,積蓄更多的能量和動力。
2、自我變革進入關鍵期華熙生物發展節奏的變化,主動調整的成分更多。
2021年、2023年,華熙生物分別對醫療終端業務、功能性護膚品業務進行了主動調整。
在2022年報媒體溝通會上,趙燕曾公開表示,醫美行業這兩年處於整頓期,2021年她主動給醫美踩了一腳剎車,讓業務提質、修煉內功。
在“修煉內功”期間,華熙生物主動收緊醫美業務,進行戰略調整,豐富產品佈局,積極申報三類醫療器械產品,在國家對醫美行業的管控背景下,推動業務向更健康、穩健方向發展。
2023年上半年,醫療終端業務在經歷回調後,開始恢復高增長,報告期內實現收入4.89億元,同比增長63.11%。
2023年全年,華熙生物醫療終端業務依然保持高速增長,全年實現收入 10.90億元,同比增長高達58.95%。
而2023年開始的護膚品業務調整,還在進行中,公司重點致力於優化以大單品為核心的品類體系、深化品牌價值;提高對多品牌資源的統籌管理,提升資源使用效率,為各大品牌差異化經營和有序成長賦能等。
以美妝為主的C端業務,“原來的增長模式,我認為存在一些問題。如果我們不去主動調整、變革,可能得到的收入數據還會沿着行業的增長慣性向前發展一段時間,問題不會在2023年顯露得那麼的突出。但如果我們不主動變革,踩上一腳剎車,去解決存在的問題,積累下去會出現更大的問題。”趙燕如是説。
不僅僅是具體業務層面的調整,2023年,華熙生物還在公司整體運營層面,進行大刀闊斧的變革,並提出五大戰略任務,來確保公司從過去的高速發展向高質量發展轉型。
財報顯示,華熙生物五大戰略任務包括數字化轉型、組織能力提升、合規經營、安全運營和降本增效。
以數字化轉型為例,華熙生物依託數據指標看板搭建各層級數據運營與支持團隊,並建立數據採集、業務指標邏輯對齊、數據運營會議的機制。基於BI視覺、OKR、端到端等各類工具持續積累數據,公司各項核心指標進一步優化,提升業務與數據對齊效率,有效支撐公司變革和組織流程的全面推動。
此外,華熙生物還啓動多個管理變革項目,包括大運營管理體系、集中採購體系、人力資源管理體系等多個關鍵領域的變革。
隨着變革的持續推進,2024年也被華熙生物內部視為變革元年,劍指業務健康度、可持續性以及發展質量等關鍵指標。
種種跡象表明,華熙生物內部變革已然進入關鍵階段。
3、迴歸底層邏輯,打造新質生產力歷史發展很多時候呈現出螺旋式上升的規律,拉長時間來看,企業發展也是如此。
階段性的回調或下滑,並不能決定企業整體的發展軌跡,關鍵還是要看其底盤是否穩固,未來是否具備可持續發展的可能。
在業務、運營變革的同時,華熙生物在底層實力構建上的步伐從未停止。
華熙生物高度注重基礎研究和應用基礎研究,在原有微生物發酵和交聯兩大核心技術平台上,公司又分別組建了中試轉化平台、配方工藝研發平台、合成生物學研發平台、應用機理研發平台四大自主研發平台。
在現有研發平台的基礎上,華熙生物持續推動合成生物戰略佈局的落地,推動新原料產品上市。
2023年,華熙生物共上市9種生物活性物原料新產品,包括3款醫藥/醫療器械級原料、4款個人護理原料、2款食品級原料。此外,還有多款產品完成試產和中試。
除了長期深耕的透明質酸領域外,華熙生物還在膠原蛋白、麥角硫因、人乳寡糖等六大類物質上取得了顯著成果,已經建立起約百餘種活性物質庫。在產學研合作方面,華熙生物積極與國內外20餘家知名科研院校展開合作,共同推動合成生物領域的研究,加快產業轉化和成果落地。

作為以合成生物科技為驅動的生物科技公司和生物材料公司,華熙生物在發展新質生產力方面正展現出卓越的能力。
所謂新質生產力,根據官方釋義是指有別於傳統生產力,以創新為主導作用,擺脱傳統經濟增長方式、生產力發展路徑,具有高科技、高效能、高質量特徵,符合新發展理念的先進生產力質態。
新質生產力本質上是一種綠色生產力。合成生物學的綠色底色,與新質生產力的理念不謀而合。
華熙生物作為國內為數不多的集合成生物研發創新能力、中試和產業化能力、市場轉化能力於一體的全產業鏈企業,正以其領先的技術和市場佈局,助力新質生產力的發展。
**在夯實底層實力的過程中,華熙生物研發投入也不斷加大,**2023年研發費用4.46億元,同比增長14.98%。研發費用率7.34%,同比2022年的6.1%,提升1.24個百分點。

華熙生物高質量、可持續的發展路徑,正在從戰略、運營、研發等方面全面落地。而公司2024年正式發佈的首份《2023年可持續發展報告》,則讓市場對華熙生物可持續發展理念和實踐,有了更為深入地瞭解。
該報告對ESG內容的披露進行了全面優化和升級,通過七大板塊詳盡地展示了華熙生物在內部管理、公司治理、科技創新、員工福利、環境保護、社會責任等方面的努力和成果,內容的豐富性和深度,以及信息的全面性和透明度,都得到大幅提升,實現與國際標準接軌。
可持續、高質量的發展,對於華熙生物而言不是一句口號,而是落實到從戰略到實踐的方方面面。這也構築着華熙生物能夠在高速發展的過程中進行自我變革的底氣。
正如醫學美容通過先一定程度破壞皮膚從而激發內生動力、產生更多有利成分讓皮膚煥新一樣,有勇氣變革、打破過去成績並苦練內功的公司,才能更為清晰地審視自己、破舊立新,在未來走得更穩、更好。